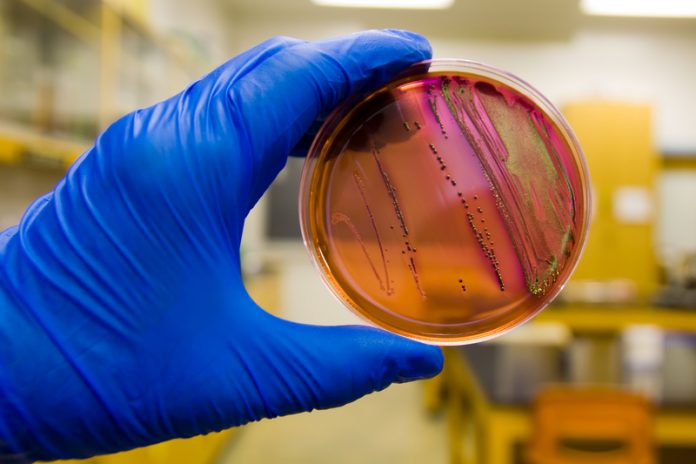

Renata Clarke, Sarah Cahill, and Jeffrey LeJeune, from the Food and Agriculture Organization of the United Nations, outline the relationship between food safety and antimicrobial resistance
The development and spread of antimicrobial resistant organisms is a complex phenomenon. Antimicrobial resistance is known to develop naturally but extensive use of antimicrobials in human medicine, animal husbandry, animal health, aquaculture, crop production, food production, and personal hygiene, among others, drives selective pressure for the spread of antimicrobial resistant organisms. Continued effectiveness of antimicrobials is critical for human, animal and plant health: thus the goal is to ensure their correct and prudent use in order to contain the development and spread of antimicrobial resistance and protect the critical benefits to human health, animal health and agricultural and food production.
A ‘one health’ perspective
Given the scale and the scope of antimicrobial use, the challenges to containing antimicrobial resistance are considerable: there needs to be broad-based commitment across disciplines and sectors to gather, analyse and share information that enables a better understanding of the phenomenon and to examine practices and develop approaches for reducing antimicrobial use. The accumulation of antimicrobial residues and the development of antimicrobial resistant organisms in the environment further complicate the complex routes by which antimicrobial resistance (AMR) can spread. For example, contamination of water and soils with bio solids and animal wastes increases the likelihood of waterborne infections and exposure to antimicrobial resistance bacteria via other environmental pathways.
The impetus for dealing with this complex situation derives from the magnitude of the problem. It is estimated that if current practices continue unchecked, by 2050 there would be 10 million AMR-related deaths annually and that the economic loss would exceed 1% of global GDP. Widespread awareness of the situation is essential to catalyse concerted global action to combat the spread of AMR.
Antimicrobial resistance: how is it related to food safety?
Food is a potential route of exposure to antimicrobial resistant organisms for everyone. The ways foods are produced, harvested, stored, and prepared are important factors in the development and spread of antimicrobial resistance. Food contaminated with resistant pathogenic organisms can result in human illness, which may not respond to the available antimicrobial treatments. Moreover, even antimicrobial resistant microorganisms that do not cause illness can contribute to the problem because they may serve as a reservoir of antimicrobial resistance traits that can be transmitted to pathogenic organisms present in foods or in people. The growing population and changing consumption patterns are putting increased demands on our food supply chains and food systems.
The diversity and variety of food production systems provide innumerable niches for the growth of microbial populations and the selection antimicrobial resistant bacteria. Of key concern is the use of antimicrobials in the production of meat and poultry, in aquaculture systems, and in crop production. The use of sanitisers and biocides through the food chain may also further contribute to AMR.
Effective management of food safety is based on the reliable application of good hygiene practices at all stages of the food chain. As such, food safety management practices are critical in limiting microbiological contamination and in reducing the occurrence of infection during primary production that leads to reduced need to use antibiotics. The food safety community has a fundamental role in combatting the spread of AMR.
Exploring the role of food safety in addressing AMR
The importance of hygiene
The cornerstone of effective control of foodborne AMR depends on the application of good hygienic practices (GHP) starting at primary production and continuing through to consumption. The Codex Code of Practice to Minimize and Contain Antimicrobial Resistance provides guidance to countries on measures to be adapted, as appropriate, and applied within countries. This Guidance includes proven methods to reduce microbial contamination of foods, such as environmental sanitation and worker hygiene, which also lower the numbers of AMR bacteria entering the food chain. There are many examples of enhanced application of basic hygiene measures during primary production leading to considerable reduction of antimicrobial use and hence a reduction of the pressure for the selection of resistant organisms spreading through the food chain.
Notions of GHP will evolve as more information becomes available on the mechanisms and the routes of the transfer of AMR traits, for instance, and on the development of alternatives to antimicrobial use in agriculture that maintain animal and plant health and productivity. At its 39th Session in 2016, the Codex Alimentarius Commission established a Task Force to consider the updating of its existing Code of Practice as well as other guidance relevant to the containment of AMR.
The need for coherent “food chain governance” at national level
Effective food safety management along the entire food chain is an essential element to any programme aiming at the containment of AMR. Official systems of food control provide guidance and the regulatory basis for these management practices and they also provide the oversight and monitoring necessary to ensure that the practices have the expected impact and they are invested with the authority to take action when problems arise. In many developing countries, national systems of food control are often fragmented and poorly coordinated, which challenges their capacity to ensure effective management of foodborne risks. Relevant regulation and its enforcement does not pertain only to hygiene practices but also to such things are the authorisation, marketing and use of veterinary drugs and pesticides with antimicrobial functions. Weak regulation enables poor management and misuse of these chemicals is further complicated by easier access to counterfeit drugs. Increased investment in strengthening systems of food control in developing countries is essential.
Building and sharing intelligence to better combat AMR
There are still many gaps in our understanding about the origin and spread of AMR along the food chain. It is necessary to gain better insights through integrated monitoring and surveillance systems programs which coordinate testing of samples from food animals, foods and humans for resistant organisms, as well as collating other relevant information such as on management practices, particularly antimicrobial use, and environmental factors.
The sharing of challenges, evidence, and solutions to combat AMR across food and non-food sectors will increase our understanding of the problem and lead to more robust solutions to the threat AMR presents to public health.
Renata Clarke, Sarah Cahill and Jeffrey LeJeune
Food and Agriculture Organization of the United Nations